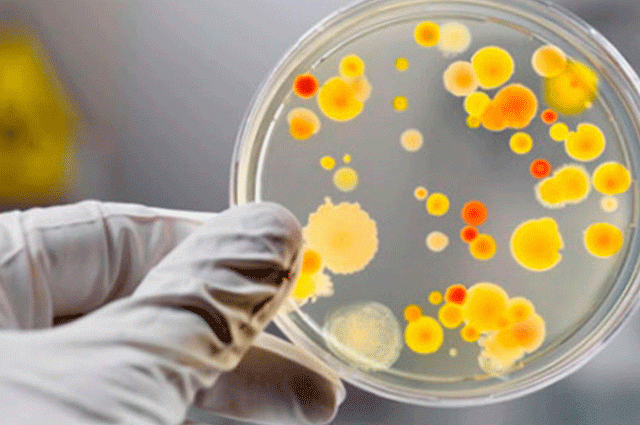
На території Вінниці зареєстровано 3 випадки сальмонельозу: замовляли їжу в кафе здорового харчування

Головне управління Держпродспоживслужби у Вінницькій області повідомляє, про те, що у Вінниці було зареєстровано три випадки сальмонельозу серед дорослих жителів міста.
За наданою інформацією, з 03.06.2021р. по 04.06.2021р. вони замовляли доставку їжі з закладу громадського харчування "НЕF кафе" по вул. Кропивницького, 7 м. Вінниця.
Фахівцями Вінницького міського управління Головного управління Держпродспоживслужби у Вінницькій області 11.06.2021р. було проведено позапланове інспектування потужності та відібрано 13 проб сировини: 1 проба води питної, 15 змивів з об’єктів внутрішнього середовища, всіх працівників закладу обстежено на бацилоносійство. Станом на 14.06.2021р. всі зразки знаходяться на стадії дослідження, в ході інспектування були виявлені грубі порушення законодавства у сфері безпечності харчових продуктів.
Довідково: "HEF кафе" позиціонується як заклад правильного, здорового харчування.
За рішенням Головного державного інспектора Вінницької області з 11.06.2021р. зачинений на 10 днів для усунення виявлених порушень, на власника закладу складено протокол та виданий припис про усунення порушень вимог законодавства про харчові продукти. Відповідальність за порушення, передбачена п.1 ч.1 ст.65 ЗУ "Про державний контроль за дотриманням законодавства про харчові продукти, корми, побічні продукти тваринного походження, здоров’я та благополуччя тварин" та тягне за собою накладання штрафу на фізичних осіб-підприємців у розмірі шести мінімальних заробітних плат (36 000 гривень).